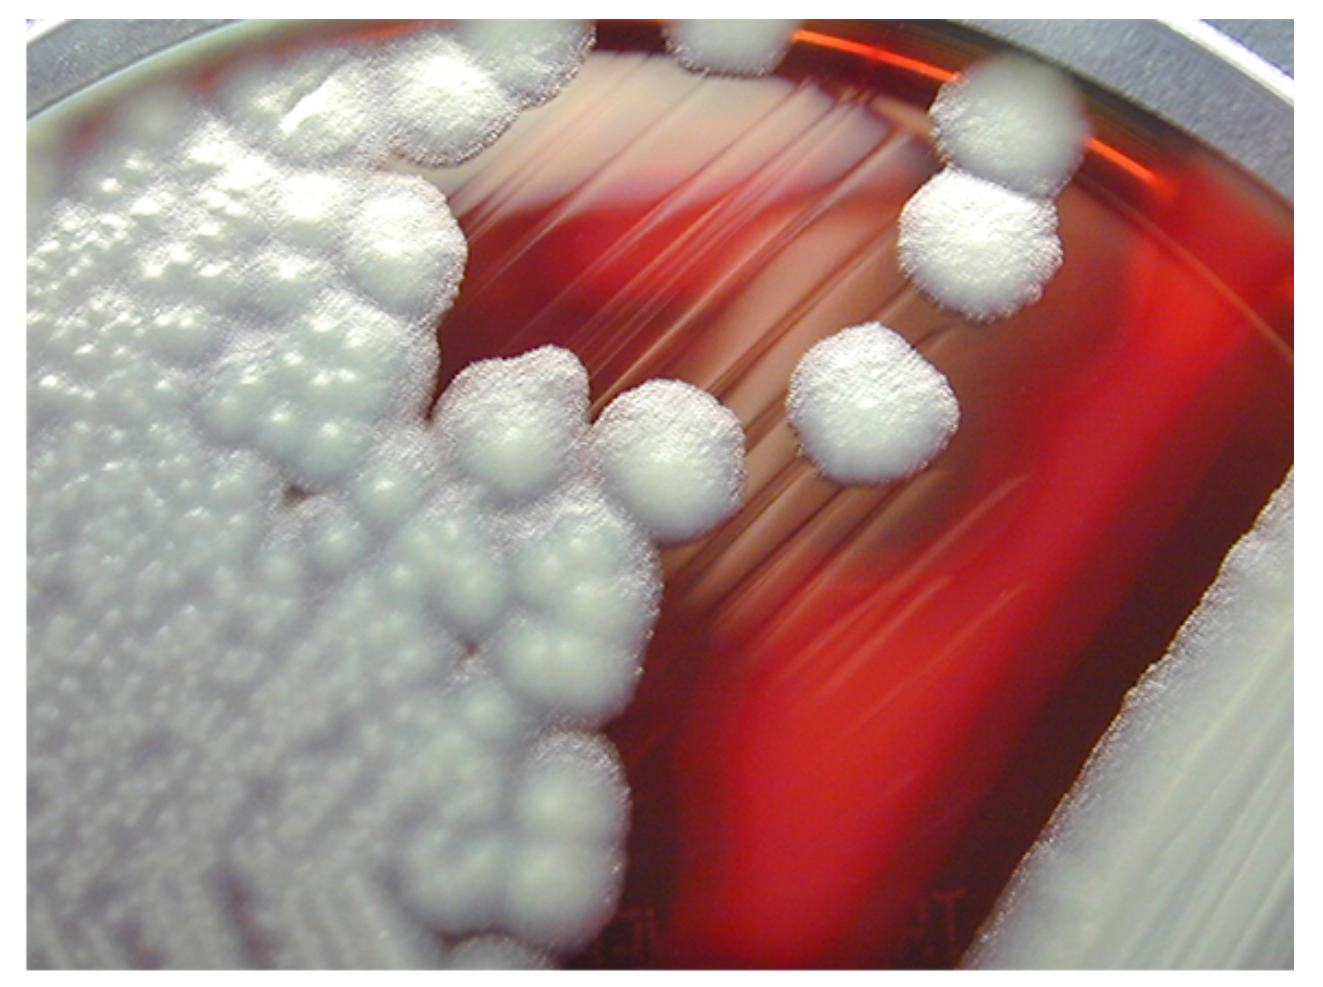

Bacillus cereus is a common spore-forming, Gram-positive bacterium found in soil, dust, and many food products, notorious for causing foodborne illnesses through toxin production. In clinical and food microbiology laboratories, identification often begins with observing its growth on sheep blood agar, where it displays distinctive colony features that facilitate rapid presumptive diagnosis. The image captures the classic appearance of B. cereus colonies on this medium, illustrating both dense growth patterns and isolated colonies that highlight key morphological traits used for differentiation from other Bacillus species.
White colonies of Bacillus cereus appear opaque, raised, and creamy-white to grayish on sheep blood agar. These colonies typically measure 2-5 mm or larger in diameter after 24 hours of incubation and exhibit a rough, matted or granular texture with irregular edges. In the image, the prominent rounded white colonies on the right and the dense clustered growth on the left demonstrate the organism’s vigorous proliferation on the nutrient-rich medium.
Sheep blood agar is a differential medium containing 5% defibrinated sheep blood that supports the growth of fastidious organisms while revealing hemolytic activity. The deep red color in the image comes from intact erythrocytes embedded in the agar base, providing a vivid contrast against the bacterial colonies. This medium is particularly useful for observing beta-hemolysis patterns produced by many strains of B. cereus through secretion of hemolysins.
Colony morphology in the image shows a mix of isolated, dome-shaped colonies and a large, spreading mass of growth with a textured surface. Individual colonies often have feathery or irregular margins due to motility and swarming tendencies under certain conditions. The overall appearance—large size, opacity, and rough texture—is highly characteristic and helps distinguish B. cereus from non-hemolytic or smoother-colony-forming relatives like Bacillus anthracis.
Microbiological Features of Bacillus cereus on Culture Media
When grown on sheep blood agar at 35-37°C, Bacillus cereus produces large, flat to slightly raised colonies that are dull gray to white with a ground-glass or frosted appearance. The colonies frequently display beta-hemolysis, creating clear zones around the growth where red blood cells are completely lysed. Although hemolysis is not explicitly labeled in the image, the medium’s red background allows easy visualization of any clearing that may surround the white colonies.
The organism is facultative anaerobic and grows rapidly, often reaching visible colonies within 18-24 hours. Motility contributes to the irregular, spreading edges seen in some strains, while spore formation confers resistance to heat and environmental stresses, explaining its persistence in improperly stored foods. The dense white growth on the left side of the image likely represents heavy inoculation or confluent growth, while the discrete colonies on the right illustrate typical isolated colony morphology.
- Colonies are opaque with a rough, matted surface that may appear granular under magnification.
- Beta-hemolysis is usually strong and wide, resulting from multiple hemolysin toxins including hemolysin BL.
- Temperature range for growth is broad, but optimal colony development occurs around body temperature.
Pathogenesis and Foodborne Illness Caused by B. cereus
Bacillus cereus produces two main types of food poisoning: the emetic syndrome and the diarrheal syndrome. The emetic form is caused by the preformed, heat-stable cereulide toxin, leading to sudden nausea and vomiting within 1-6 hours after consuming contaminated food, commonly fried rice or pasta left at room temperature. The diarrheal syndrome results from heat-labile enterotoxins produced in the gut, causing watery diarrhea and cramps 8-16 hours post-ingestion.
In addition to gastroenteritis, B. cereus can cause invasive infections such as endophthalmitis, bacteremia, pneumonia, and wound infections, especially in immunocompromised hosts or following trauma. Its virulence factors include phospholipases, proteases, and multiple enterotoxins that damage host tissues and modulate immune responses. The robust colony growth shown in the image reflects the organism’s ability to proliferate quickly in favorable conditions, mirroring its behavior in contaminated food.
- Emetic toxin is a cyclic peptide highly resistant to cooking temperatures and gastric acid.
- Diarrheal toxins are proteins destroyed by thorough heating but produced in vivo.
- Opportunistic infections often involve biofilm formation on medical devices.
Laboratory Identification and Differentiation
Observation of white colonies on sheep blood agar provides a strong presumptive clue for Bacillus cereus. The image highlights the typical large, opaque colonies that prompt further testing on selective media like mannitol egg yolk polymyxin (MYP) agar, where lecithinase-positive colonies produce opaque halos. Gram staining reveals large Gram-positive rods in chains, confirming the morphology consistent with the Bacillus genus.
Key biochemical tests include positive catalase, Voges-Proskauer, motility, and lecithinase activity. Unlike Bacillus anthracis, B. cereus is motile, penicillin-resistant, and strongly beta-hemolytic. Molecular methods targeting toxin genes offer rapid confirmation in outbreak investigations. The colony features captured in the image are essential for initial differentiation in busy diagnostic laboratories.
- Colonies on blood agar are larger and more irregular than those of many other Gram-positive bacteria.
- Swarming motility can produce feathery extensions from the main colony mass.
- Spore staining reveals central to subterminal endospores that do not markedly distend the cell.
Clinical Management, Prevention, and Public Health
Most B. cereus food poisoning cases are self-limited, requiring only supportive therapy with oral rehydration. Severe diarrheal or emetic episodes may need antiemetics or intravenous fluids. Invasive infections demand prompt antibiotic treatment, commonly with vancomycin, clindamycin, or ciprofloxacin, combined with source control in cases like wound debridement or removal of infected devices.
Prevention relies on good food hygiene practices: cooking foods thoroughly, cooling leftovers rapidly to below 4°C, and reheating to at least 74°C before consumption. In food processing, proper pasteurization and storage temperatures minimize spore germination and toxin production. Healthcare facilities emphasize disinfection and sterile techniques to prevent nosocomial spread.
Public health authorities investigate outbreaks by culturing suspect foods and patient samples, using the distinctive colony morphology on blood agar as an early indicator. Education campaigns focus on the risks of temperature abuse in rice-based dishes and other starchy foods that support rapid B. cereus growth.
The image serves as an excellent educational resource, clearly demonstrating the macroscopic features that microbiologists rely upon daily. Recognizing these white colonies on the red background of sheep blood agar accelerates identification and guides appropriate clinical and food safety responses.
In conclusion, Bacillus cereus remains a significant yet often underappreciated pathogen whose laboratory presentation on blood agar provides critical diagnostic information. Mastery of its colony characteristics, combined with an understanding of its toxin-mediated diseases, equips healthcare and food safety professionals to mitigate its impact effectively.

